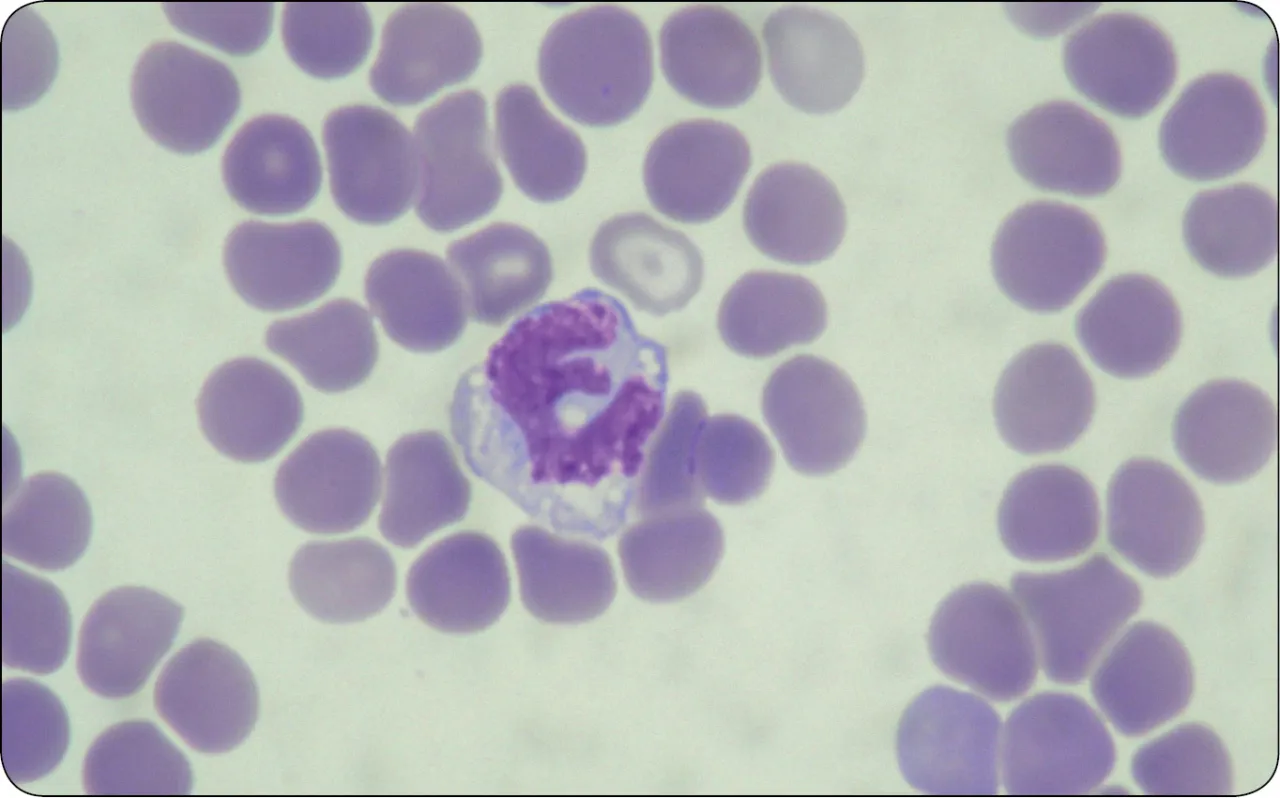
rozmaz krwi obwodowej pod mikroskopem

Otrzymałeś wyniki rozmazu krwi obwodowej i zastanawiasz się, co oznaczają poszczególne parametry? Ten artykuł to przystępny przewodnik, który pomoże Ci zrozumieć podstawy interpretacji, wyjaśniając znaczenie skrótów i norm, zanim skonsultujesz się z lekarzem.
Samodzielne odczytanie rozmazu krwi wstępne zrozumienie wyników badań
- Rozmaz krwi to szczegółowe badanie morfologii i budowy komórek krwi, uzupełniające podstawową morfologię.
- Analizuje się erytrocyty (RBC), leukocyty (WBC) z podziałem na podtypy (neutrofile, limfocyty, monocyty, eozynofile, bazofile) oraz trombocyty (PLT).
- Kluczowe jest porównywanie wyników z normami referencyjnymi podanymi przez konkretne laboratorium.
- Odchylenia od normy mogą wskazywać na infekcje, alergie, stany zapalne lub inne schorzenia.
- Interpretacja wartości bezwzględnych leukocytów jest ważniejsza niż procentowych.
- Samodzielna analiza jest jedynie wstępna i nigdy nie zastąpi profesjonalnej diagnozy lekarskiej.
Kiedy zwykła morfologia to za mało: rola badania mikroskopowego
Zwykła morfologia krwi, choć niezwykle ważna, czasem potrzebuje uzupełnienia. Właśnie wtedy do akcji wkracza rozmaz krwi obwodowej, często wykonywany manualnie, czyli pod mikroskopem. Jest to badanie zlecane przez lekarza, gdy automatyczna analiza morfologii wykaże pewne nieprawidłowości lub gdy istnieje podejrzenie konkretnych schorzeń. Jego główną rolą jest szczegółowa ocena nie tylko ilości, ale przede wszystkim budowy (morfologii) oraz dojrzałości poszczególnych komórek krwi: erytrocytów (krwinek czerwonych), leukocytów (krwinek białych) i trombocytów (płytek krwi). Dzięki temu badaniu diagnosta może dostrzec subtelne zmiany, które są kluczowe dla postawienia trafnej diagnozy, a których automat mógłby nie wychwycić.
Różnica między rozmazem automatycznym a manualnym: co to oznacza dla Ciebie?
Warto wiedzieć, że rozmaz krwi obwodowej może być wykonany na dwa sposoby: automatycznie przez analizator lub manualnie przez doświadczonego diagnostę laboratoryjnego. Rozmaz automatyczny jest szybszy i stanowi standardowe uzupełnienie morfologii. Jednak to właśnie rozmaz manualny (mikroskopowy) jest nieoceniony, gdy potrzebna jest precyzyjna ocena morfologii komórek. Diagnosta ogląda pod mikroskopem próbkę krwi, oceniając kształt, wielkość, zabarwienie, a także obecność ewentualnych patologicznych form komórek. To właśnie ta wizualna analiza pozwala wychwycić zmiany, które są często kluczowe w diagnostyce wielu chorób krwi, infekcji czy stanów zapalnych.
Jak prawidłowo przygotować się do badania, by wynik był wiarygodny?
Aby Twoje wyniki rozmazu krwi były jak najbardziej wiarygodne, warto pamiętać o kilku prostych zasadach przygotowania do badania:
- Krew powinna być pobierana na czczo, co oznacza, że przez co najmniej 8-12 godzin przed badaniem nie należy nic jeść.
- Badanie najlepiej wykonać w godzinach porannych (między 7:00 a 10:00).
- Przed pobraniem krwi unikaj intensywnego wysiłku fizycznego i stresu.
- Poinformuj lekarza o wszystkich przyjmowanych lekach, suplementach i ziołach, ponieważ mogą one wpływać na wyniki.
Przestrzeganie tych zaleceń minimalizuje ryzyko zafałszowania wyników i pozwala na ich rzetelną interpretację.

Jak samodzielnie wstępnie odczytać wyniki rozmazu krwi?
Zrozumieć legendę: skróty, jednostki i zakresy referencyjne
Gdy otrzymujesz wydruk wyników badań, na pierwszy rzut oka może on wyglądać jak zbiór tajemniczych symboli. Spokojnie! Pierwszym krokiem do wstępnej interpretacji jest zrozumienie "legendy". Na wydruku znajdziesz skróty (np. WBC dla leukocytów, RBC dla erytrocytów, PLT dla trombocytów, NEU dla neutrofili, LYM dla limfocytów), jednostki miary (np. G/L, % czy fL) oraz, co najważniejsze, zakresy referencyjne (normy). To właśnie te zakresy są Twoim punktem odniesienia. Zanim zaczniesz analizować swoje liczby, upewnij się, że wiesz, co oznaczają poszczególne skróty i w jakich jednostkach podane są wartości.
Dlaczego normy z Twojego laboratorium są najważniejsze?
To bardzo ważna kwestia, o której często zapominamy, szukając informacji w internecie. Pamiętaj, że każde laboratorium diagnostyczne podaje na wydruku wyniku własne zakresy referencyjne. Mogą się one nieznacznie różnić w zależności od stosowanej aparatury, metodologii badań, a nawet populacji, na której zostały ustalone. Dlatego też, gdy próbujesz wstępnie zinterpretować swoje wyniki, zawsze odnoś się do norm podanych na konkretnym wydruku z Twojego laboratorium. Porównywanie ich z ogólnymi normami znalezionymi w internecie może prowadzić do błędnych wniosków i niepotrzebnego niepokoju.
Flagi przy wynikach (H/L): Twój pierwszy sygnał do zwrócenia uwagi
Często obok wyników, które odbiegają od normy, pojawiają się specjalne oznaczenia, tzw. "flagi". Najczęściej spotykane to "H" (od ang. high) oznaczające wartość podwyższoną lub "L" (od ang. low) sygnalizujące wartość obniżoną. Te flagi są dla Ciebie pierwszym, wyraźnym sygnałem, że dany parametr wykracza poza przyjęte normy. Warto na nie zwrócić uwagę, ale nie traktuj ich od razu jako powód do paniki. Flaga oznacza jedynie odchylenie statystyczne, a jego znaczenie kliniczne oceni dopiero lekarz, biorąc pod uwagę cały obraz Twojego zdrowia.
Erytrocyty (RBC): co mówią o zdrowiu czerwone krwinki?
Nie tylko ilość się liczy: co diagnosta ocenia pod mikroskopem?
Choć liczba erytrocytów (RBC) jest ważna, to w rozmazie krwi obwodowej diagnosta zagląda znacznie głębiej. Pod mikroskopem ocenia on nie tylko ich ilość, ale przede wszystkim morfologię, czyli wygląd i budowę krwinek czerwonych. Zwraca uwagę na:
- Wielkość: Czy są prawidłowe (normocytoza), zbyt małe (mikrocytoza) czy zbyt duże (makrocytoza)? Ocenia także, czy występują znaczące różnice w wielkości (anizocytoza).
- Kształt: Czy mają prawidłowy kształt dwuwklęsłego dysku, czy może są sierpowate, tarczowate, owalne lub mają inne, patologiczne formy (poikilocytoza)?
- Zabarwienie: Czy są prawidłowo zabarwione (normochromia), zbyt blade (hipochromia) czy nadmiernie intensywnie (hiperchromia)?
- Obecność patologicznych wtrętów: Czy wewnątrz krwinek nie ma żadnych nieprawidłowych struktur, które mogłyby wskazywać na konkretne schorzenia.
Te szczegółowe obserwacje są kluczowe dla diagnostyki wielu chorób.
Anizocytoza i poikilocytoza: tajemnicze terminy dotyczące wielkości i kształtu krwinek
Kiedy czytasz opis rozmazu, możesz natknąć się na terminy takie jak anizocytoza i poikilocytoza. Czym one są?
Anizocytoza to nic innego jak różnice w wielkości erytrocytów. Oznacza to, że krwinki czerwone w Twojej krwi nie są jednolite pod względem rozmiaru obok siebie mogą występować zarówno mniejsze, jak i większe komórki. Może to wskazywać na zaburzenia w procesie ich produkcji w szpiku kostnym.
Z kolei poikilocytoza odnosi się do różnic w kształcie erytrocytów. Zamiast typowych, okrągłych dysków, diagnosta może zaobserwować krwinki o nietypowych formach, np. sierpowate, tarczowate, kolczaste. Zarówno anizocytoza, jak i poikilocytoza są niespecyficznymi wskaźnikami, które mogą towarzyszyć wielu typom niedokrwistości i innym chorobom wpływającym na produkcję lub żywotność krwinek czerwonych.
Co mogą sugerować zmiany w wyglądzie czerwonych krwinek?
Nieprawidłowości w wyglądzie erytrocytów, które diagnosta dostrzeże pod mikroskopem, mogą być cenną wskazówką dla lekarza. Mogą one sugerować:
- Różne typy niedokrwistości (anemii): Na przykład mikrocytoza i hipochromia często towarzyszą niedokrwistości z niedoboru żelaza, natomiast makrocytoza może wskazywać na niedokrwistość megaloblastyczną (z niedoboru witaminy B12 lub kwasu foliowego).
- Choroby wątroby: Niektóre zmiany w kształcie erytrocytów mogą być związane z zaburzeniami funkcji wątroby.
- Zatrucia metalami ciężkimi: Na przykład zatrucie ołowiem może powodować specyficzne wtręty w erytrocytach.
- Zaburzenia czynności szpiku kostnego: Nieprawidłowa produkcja krwinek w szpiku może objawiać się ich nietypowym wyglądem.
Pamiętaj, że są to jedynie sugestie, a ostateczna diagnoza zawsze wymaga kompleksowej oceny.
Leukocyty (WBC): biali strażnicy Twojej odporności
Dlaczego wartości bezwzględne są ważniejsze niż procenty?
Kiedy analizujesz wyniki dotyczące leukocytów (WBC), czyli białych krwinek, kluczowe jest zrozumienie jednej zasady: wartości bezwzględne poszczególnych subpopulacji leukocytów są znacznie ważniejsze niż ich wartości procentowe. Dlaczego? Ponieważ wartość procentowa mówi jedynie o tym, jaki odsetek wszystkich białych krwinek stanowi dany typ. Jeśli ogólna liczba leukocytów jest niska, nawet wysoki procent danego typu komórek może oznaczać ich faktyczny niedobór w organizmie. I odwrotnie niski procent przy bardzo wysokiej ogólnej liczbie WBC może wciąż oznaczać prawidłową, a nawet podwyższoną liczbę bezwzględną. Dlatego zawsze zwracaj uwagę na kolumnę z wartościami bezwzględnymi (często podawanymi w G/L lub x10^9/L).
Neutrofile (NEU): pierwsza linia obrony przed bakteriami
Neutrofile to najliczniejsza grupa białych krwinek i stanowią pierwszą linię obrony organizmu, szczególnie przed infekcjami bakteryjnymi i grzybiczymi. Ich orientacyjna norma dla dorosłych to 45-70% wszystkich leukocytów, ale pamiętajmy o wartościach bezwzględnych. Wzrost poziomu neutrofili (neutrofilia) najczęściej obserwujemy w przypadku ostrych infekcji bakteryjnych, stanów zapalnych (np. zapalenie wyrostka robaczkowego), urazów, oparzeń czy silnego stresu. Z kolei spadek poziomu neutrofili (neutropenia) może być sygnałem infekcji wirusowych (np. grypy), uszkodzenia szpiku kostnego (np. przez leki, chemioterapię) lub chorób autoimmunologicznych. Zawsze warto skonsultować takie odchylenia z lekarzem.
Limfocyty (LYM): Twoi specjaliści od walki z wirusami i nowotworami
Limfocyty to kolejna ważna grupa białych krwinek, odgrywająca kluczową rolę w odporności. Są to specjaliści od walki z wirusami, a także od rozpoznawania i eliminowania komórek nowotworowych. Ich orientacyjna norma dla dorosłych to 15-45%. Wzrost poziomu limfocytów (limfocytoza) jest bardzo typowy dla infekcji wirusowych, takich jak mononukleoza zakaźna, różyczka czy wirusowe zapalenie wątroby. Może także towarzyszyć przewlekłym zakażeniom czy niektórym białaczkom. Natomiast spadek poziomu limfocytów (limfopenia) może wskazywać na niedobory odporności (np. w przebiegu zakażenia HIV), stosowanie leków immunosupresyjnych czy w stanach wyniszczenia organizmu. Są to parametry, które zawsze wymagają uwagi.
Monocyty (MON): "sprzątacze" organizmu, kiedy ich poziom rośnie?
Monocyty to duże białe krwinki, które pełnią funkcję "sprzątaczy" w organizmie. Ich głównym zadaniem jest fagocytoza, czyli pochłanianie i trawienie patogenów, resztek komórkowych oraz obcych cząstek. Są również ważne w prezentacji antygenów, inicjując odpowiedź immunologiczną. Orientacyjna norma dla dorosłych to 2-8%. Wzrost poziomu monocytów (monocytoza) często towarzyszy przewlekłym zakażeniom bakteryjnym (np. gruźlica, kiła), chorobom autoimmunologicznym (np. reumatoidalne zapalenie stawów), a także niektórym chorobom nowotworowym, w tym białaczkom. Ich podwyższony poziom może być sygnałem, że organizm intensywnie walczy z jakimś procesem chorobowym.
Eozynofile (EOS): niezawodny wskaźnik alergii i pasożytów
Eozynofile to białe krwinki, które w rozmazie krwi są stosunkowo nieliczne, z orientacyjną normą dla dorosłych wynoszącą 1-5%. Są one jednak niezwykle ważne w reakcjach alergicznych oraz w obronie przed pasożytami. Wzrost poziomu eozynofili (eozynofilia) jest bardzo charakterystyczny dla chorób alergicznych, takich jak astma, atopowe zapalenie skóry czy katar sienny. Często obserwujemy go także w przypadku zakażeń pasożytniczych (np. owsica, tasiemczyca). Eozynofilia może również towarzyszyć niektórym chorobom skóry, chorobom autoimmunologicznym, a rzadziej nowotworom. Ich podwyższony poziom to zazwyczaj wyraźny sygnał dla lekarza, by poszukać przyczyny w alergii lub infekcji pasożytniczej.
Bazofile (BAS): rzadko spotykane, ale istotne w reakcjach alergicznych
Bazofile to najmniej liczna grupa białych krwinek, stanowiąca zaledwie 0-3% wszystkich leukocytów w rozmazie krwi dorosłego człowieka. Ich rola jest ściśle związana z reakcjami alergicznymi, zwłaszcza tymi natychmiastowymi, oraz z przewlekłymi stanami zapalnymi. Bazofile uwalniają histaminę i inne substancje aktywne, które biorą udział w odpowiedzi immunologicznej. Wzrost poziomu bazofili (bazofilia) jest zjawiskiem rzadkim. Może być związany z ciężkimi reakcjami alergicznymi, ale również z przewlekłymi stanami zapalnymi, niedoczynnością tarczycy, a w niektórych przypadkach z chorobami rozrostowymi szpiku kostnego. Ze względu na ich niewielką liczbę, nawet niewielkie odchylenia od normy mogą być istotne i wymagają dalszej diagnostyki.
Trombocyty (PLT): rola płytek krwi w organizmie
Rola trombocytów w procesie krzepnięcia: dlaczego są tak ważne?
Trombocyty, czyli płytki krwi (PLT), to niewielkie, bezjądrzaste elementy krwi, które odgrywają absolutnie kluczową rolę w procesie krzepnięcia krwi i utrzymaniu integralności naczyń krwionośnych. Kiedy naczynie krwionośne zostanie uszkodzone, płytki krwi natychmiast przylegają do miejsca urazu, tworząc tzw. czop płytkowy. Następnie aktywują się, uwalniając substancje, które inicjują i wzmacniają proces krzepnięcia, prowadząc do powstania skrzepu. Bez prawidłowej liczby i funkcji trombocytów, nawet niewielkie urazy mogłyby prowadzić do poważnych krwawień, dlatego ich rola jest nie do przecenienia dla naszego zdrowia i życia.
Małopłytkowość i nadpłytkowość: potencjalne przyczyny odchyleń
Nieprawidłowości w liczbie płytek krwi mogą mieć poważne konsekwencje. Wyróżniamy dwa główne stany:
- Małopłytkowość (trombocytopenia): To obniżona liczba płytek krwi. Może prowadzić do zaburzeń krzepnięcia i zwiększonej skłonności do krwawień (np. siniaki, krwawienia z nosa). Przyczyny są różnorodne, od nadczynności śledziony (która niszczy płytki), przez marskość wątroby, infekcje wirusowe, po choroby szpiku kostnego (np. białaczki, niedokrwistość aplastyczna) czy działanie niektórych leków.
- Nadpłytkowość (trombocytoza): To podwyższona liczba płytek krwi. Może zwiększać ryzyko zakrzepicy, czyli tworzenia się skrzepów w naczyniach krwionośnych. Najczęstsze przyczyny to stany zapalne, ostre infekcje, niedobór żelaza, po usunięciu śledziony, a także choroby rozrostowe szpiku kostnego.
Zarówno małopłytkowość, jak i nadpłytkowość wymagają zawsze szczegółowej diagnostyki i leczenia pod nadzorem lekarza.
Na co diagnosta zwraca uwagę w budowie płytek krwi?
Poza samą liczbą trombocytów, diagnosta laboratoryjny podczas rozmazu krwi obwodowej ocenia również ich morfologię. Zwraca uwagę na wielkość płytek (czy są prawidłowe, czy występują płytki olbrzymie), ich kształt oraz występowanie agregatów, czyli skupisk płytek. Agregaty mogą świadczyć o aktywacji płytek lub być artefaktem związanym z pobraniem krwi. Nieprawidłowości w budowie płytek mogą dostarczyć cennych informacji o funkcjonowaniu układu krzepnięcia i potencjalnych chorobach.
Samodzielna interpretacja wyników: dlaczego ostrożność jest kluczowa?
Jeden parametr to nie wyrok: jak lekarz patrzy na całość wyników
Zofia Kotowicz tutaj, i muszę to podkreślić: pojedyncze odchylenie od normy w rozmazie krwi obwodowej absolutnie nie musi oznaczać poważnej choroby! Wiem, że łatwo o niepokój, gdy widzimy "H" lub "L" przy jakimś parametrze. Jednak lekarz patrzy na Twoje wyniki w znacznie szerszym kontekście. Będzie brał pod uwagę Twoje objawy, historię medyczną, przebyte choroby, wiek, płeć, a także wyniki innych badań. Wszystkie te elementy tworzą spójny obraz kliniczny, który jest niezbędny do postawienia trafnej diagnozy i zaplanowania ewentualnego leczenia. Internetowa interpretacja, choć pomocna w zrozumieniu, nie zastąpi tej kompleksowej oceny.
Wpływ wieku, płci i stylu życia na obraz krwi
Warto pamiętać, że zakresy norm laboratoryjnych nie są uniwersalne dla wszystkich. Mogą się one różnić w zależności od wieku i płci. Na przykład, normy dla dzieci, kobiet w ciąży czy osób starszych mogą być inne niż dla dorosłych mężczyzn. Co więcej, na obraz krwi może wpływać również styl życia dieta, poziom aktywności fizycznej, używki, a nawet poziom stresu. Nawet drobne infekcje, które właśnie przechodzisz (np. przeziębienie), mogą tymczasowo zmienić niektóre parametry. To wszystko sprawia, że samodzielna interpretacja bez uwzględnienia indywidualnych czynników jest obarczona dużym ryzykiem błędu.
Kiedy odchylenia od normy są normalne, a kiedy wymagają dalszej diagnostyki?
To jest właśnie sedno problemu samodzielnej interpretacji. Niektóre odchylenia od normy mogą być całkowicie fizjologiczne i nie mieć żadnego znaczenia klinicznego. Mogą wynikać z indywidualnych cech organizmu, chwilowego stanu fizjologicznego (np. po wysiłku) lub być po prostu wariantem normy dla danej osoby. Z drugiej strony, nawet niewielkie, ale utrzymujące się odchylenia, mogą być wczesnym sygnałem poważniejszego problemu. Tylko lekarz, posiadający wiedzę medyczną i dostęp do pełnego obrazu klinicznego, jest w stanie ocenić, czy dane odchylenie jest powodem do niepokoju i czy wymaga dalszej diagnostyki. Nie próbuj stawiać sobie diagnozy na podstawie samych liczb.
Twoje wyniki badań: mapa dla lekarza, nie diagnoza online
Jak przygotować się do wizyty u lekarza z wynikami rozmazu?
Wizyta u lekarza z wynikami badań to idealna okazja, by rozwiać wszelkie wątpliwości. Aby maksymalnie wykorzystać ten czas, warto się przygotować:
- Spisz swoje objawy: Kiedy się pojawiły, jak są nasilone, co je łagodzi, a co nasila.
- Przygotuj listę pytań: Co Cię niepokoi w wynikach, czego nie rozumiesz, jakie masz obawy.
- Zabierz historię chorób: Informacje o przebytych schorzeniach, alergiach, przyjmowanych lekach i suplementach.
- Nie interpretuj na siłę: Pozwól lekarzowi na swobodną, profesjonalną analizę.
Twoja aktywność i uporządkowane informacje pomogą lekarzowi w szybszej i trafniejszej ocenie sytuacji.
Przeczytaj również: Ile się czeka na badania sanepidowskie - poznaj realne terminy wyników
Dlaczego ostateczna diagnoza należy wyłącznie do specjalisty?
Pamiętaj, że internetowa interpretacja wyników rozmazu krwi obwodowej jest jedynie wstępnym narzędziem, które ma na celu pomóc Ci zrozumieć podstawy i przygotować się do rozmowy z lekarzem. Nigdy nie może ona zastąpić profesjonalnej diagnozy medycznej. Lekarz to jedyny specjalista, który ma pełne kwalifikacje i doświadczenie, by połączyć wszystkie elementy układanki: Twoje objawy, wywiad medyczny, wyniki badań laboratoryjnych i ewentualnie obrazowych. Tylko on może postawić ostateczną diagnozę, ocenić ryzyko, zaplanować dalsze postępowanie i wdrożyć odpowiednie leczenie. Zaufaj ekspertom Twoje zdrowie jest w najlepszych rękach, gdy polegasz na wiedzy i doświadczeniu medycznym.
